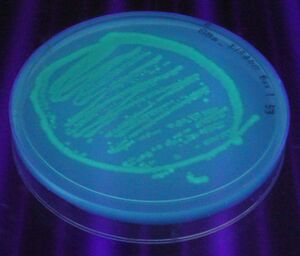

BioBricks construction tutorial
Contacts
Barry Canton, Jason Kelly, Will Bosworth
Aim
Describe the steps of a standard BioBricks assembly for two parts and include images of expected results (e.g., gels, seq files, etc). This will provide a walkthrough for someone new to BioBricks construction to practice with parts that are known to work together well.
Steps
Assumed starting point is from glycerol stocks of insert and vector.
Streak plates of insert and vector from glycerol stocks

- Antibiotic Used:
- Incubation Time:
Grow 5ml Cultures of each from a single colony
- Cellular chassis: Vector - Top10, Insert - MC4100
- Growth media: LB
- Antibiotic: Amp (5μg/ml)
- Growth Temperature: 37C
- Spin speed: 51.7rpm
- Incubation Time: 14 hours, 50mins
- Final OD600: Vector 2.60, Insert 3.56
Miniprep plasmid DNA from cultures
- Prep concentration of vector: 107.2 ng/μl (50μl elution volume)
- Prep concentration of insert: 139 ng/μl (50μl elution volume)
Restriction digest insert and vector with appropriate enzymes
- Vector restriction enzymes used:
- Insert restriction enzymes used:
- Incubation time: Heat inactivation started at 11.10am.
- Any other details of protocol that aren't included in the protocol already.
Run vector and insert on a gel
- Voltage: ?V
- Current: ?A
- Electrophoresis Time: ?mins
- Image of successful gel. Any images of failed gels can be put on the common agarose gel problems page and linked to. Of course there won't be any failed gels.
Extract vector and insert from gel
Ligate insert and vector
Transform ligation product into competent cells
Can use electroporation or chemical transformation
Screen colonies for correct plasmid by colony PCR
Tranformants should glow when exposed to UV light. Should probably point out that it's usually not this easy to screen. We can also tell them to pick a couple that glow and a couple that don't to confirm that the colony pcr does a good job at predicting a successful tranformation.
Miniprep DNA from chosen colony
Make glycerol and sequence DNA
Expected lengths? Include links to the parts registry and description of how to find parts?